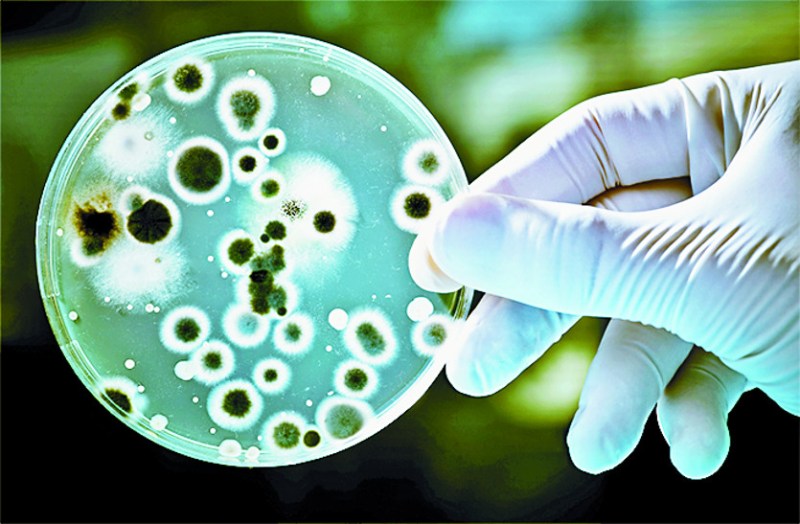

बैक्टीरिया के नाम रखने की तीन सदी पुरानी प्रणाली बदली, नई तैयार
वॉशिंगटन. अमरीकी वैज्ञानिकों ने बैक्टीरिया के नामकरण के लिए जीनोम सीक्वेंसिंग आधारित नई प्रणाली 'सीक-कोड' तैयार की है। इससे बैक्टीरिया के नामकरण की 300 साल पुरानी प्रणाली बदल गई है। दावा किया गया है कि ऐसा करने से इन सूक्ष्म जीवों को जानने में आसानी होगी। नई पीढ़ी के एंटीबायोटिक्स की पहचान से लेकर कैंसर के इलाज की खोज में भी मदद मिल सकती है।
बैक्टीरिया के नामकरण की नई प्रणाली के लिए 2018 में अमरीका में नेशनल साइंस फाउंडेशन के सहयोग से पहल की गई थी। लंबे विचार-विमर्श और अध्ययन के बाद सितंबर 2022 में इसे सीक-कोड के रूप में अपनाया गया। इस प्रणाली के बाद शुद्ध कल्चर वाले बैक्टीरिया के नामकरण की पुरानी प्रणाली भी चलती रहेगी। वैज्ञानिकों का कहना है कि बैक्टीरिया की प्रभावी, औपचारिक और स्थाई नामकरण प्रणाली से पृथ्वी पर सूक्ष्म जीवों की विविधता का पता लगाने में ज्यादा मदद मिलेगी। हमारे वातावरण में उनकी क्या भूमिका है, यह भी पता चलेगा। वैज्ञानिक किसी बैक्टीरिया के बारे में ज्यादा पुख्ता तरीके से बात कर पाएंगे।
कार्ल लिनेस की बाई-नॉमिअल प्रणाली
स्वीडन के वनस्पति वैज्ञानिक कार्ल लिनेस ने 1737 में तार्किक बाई-नॉमिअल (द्विपद) प्रणाली पेश की थी। इसमें सभी जीवों, पेड़-पौधों आदि के नाम दो हिस्सों में रखे जाते हैं। पहला हिस्सा उनका जीन्स होता है, जो सरनेम की तरह काम आता है। दूसरा हिस्सा उस प्रजाति की विशेषता बताता है। इस मेल से लगभग सभी सूक्ष्म जीवों को विशिष्ट नाम मिलना संभव हुआ। जैसे मनुष्य होमो सेपियन कहलाए।
डीएनए सीक्वेंसिंग का सहारा
इस प्रणाली के जरिए बैक्टीरिया की किसी प्रजाति को लैब में पैदा कर उसका अध्ययन करने के बजाय वैज्ञानिक उसकी डीएनए सीक्वेंसिंग का सहारा ले पाएंगे। उन्हें सूक्ष्म जीव का जीनोम हासिल होगा। इसे डीएनए का ब्लूप्रिंट कहा जाता है। इसमें किसी जीव की सारी कार्यप्रणाली मौजूद होती है। सीक्वेंसिंग के डेटा से किसी खास प्रजाति की अन्य प्रजाति से अलग पहचान में मदद मिलेगी।
Published on:
31 Oct 2022 11:43 pm
बड़ी खबरें
View Allजयपुर
राजस्थान न्यूज़
ट्रेंडिंग
